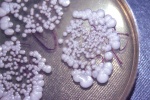

Гепатоз беременных, чем опасно заболевание
Гепатоз беременных – распространенное среди будущих мам заболевание. Недуг возникает на фоне значительного увеличения нагрузки на печень, при этом размеры и форма органа могут оставаться без изменений.

Что такое гепатоз и почему он развивается у беременных?
Гепатоз представляет собой патологию печени, при которой клетки органа перестают справляться со своими функциями в силу ряда причин. Различают два типа этого заболевания, характерных для периода беременности:
- Холестатический гепатоз беременных. Распространенная форма недуга, развивающаяся из-за дистрофических изменений на клеточном уровне и нарушения обменных процессов. Причиной состояния становится гормональная перестройка, происходящая в организме матери.
- Острый жировой гепатоз беременных. Диагностируется гораздо реже и является нарушением, при котором клетки печени замещаются жировой тканью. Болезнь возникает при сбое в усвоении жирных кислот, наличии эндокринных патологий, ожирении, алкогольной зависимости. Эта форма гепатоза наиболее опасна и представляет угрозу жизни матери и ребенка. Если болезнь протекает тяжело, может потребоваться экстренное родоразрешение.
При нормальном течении беременности и отсутствии изначальных патологий органа, печень не изменяется в размерах, сохраняет свою прежнюю структуру и оптимальный уровень кровоснабжения.
Но может нарушиться ее функционирование, так как вместе с ростом плода увеличивается нагрузка: необходимо перерабатывать не только продукты жизнедеятельности матери, но и ребенка. В дополнение к этому, к концу первого триместра печень вырабатывает большее количество гормонов.
Нагрузка на этот орган в первом триместре приводит к развитию токсикоза, а в третьем – к гепатозу. Такое состояние должно находиться под постоянным наблюдением врача, в тяжелых случаях может потребоваться госпитализация.
Для женщин, болеющих гепатозом, свойственна высокая чувствительность к выработке эстрогена. При беременности его количество увеличивается, что приводит к холестазу – состоянию, при котором нарушается процесс образования и оттока желчи. Заболевание в несколько раз увеличивает риск гибели плода.
Как проявляется гепатоз при беременности?
Холестатический гепатоз беременных чаще проявляется кожным зудом и шелушением. Этот симптом особенно сильно беспокоит женщин перед сном и ночью, усиливается после водных процедур. Также распространены жалобы на тошноту и рвоту, боль в области печени и чувство тяжести.
Женщина теряет аппетит, повышается ее утомляемость, иногда появляются головные боли, апатия. Каловые массы становятся обесцвеченными. Как правило, проявления холестатического гепатоза исчезают после родов.
При остром течении заболевания к вышеперечисленным симптомам добавляется изжога, желтуха, рвота с примесью гематина. При отсутствии медицинской помощи – кратковременные потери сознания, развитие нарушений в других органах, особенно в работе почек.
Жировой гепатоз беременных имеет следующие симптомы:
- тошнота;
- рвота;
- сонливость;
- слабость;
- тяжесть и боль в области печени.

Эта форма заболевания в запущенном состоянии может сопровождаться проффузным кровотечением. Среди других опасных проявлений значится нарастающая почечно-печеночная недостаточность.
Диагностические мероприятия
Для благополучного завершения беременности, а также сохранения здоровья матери и будущего ребенка важна своевременная диагностика гепатоза. Ее проведение осложняется рядом особенностей:
- Осмотр и опрос пациентки не дают достаточно информации о заболевании, так как симптомы гепатоза свойственны и для других заболеваний. Приступы тошноты и рвоты характерны для токсикоза, шелушение кожи и зуд сопровождают аллергические реакции и нервные расстройства. Острая форма гепатоза по нескольким признакам совпадает с проявлениями вирусного гепатита.
- Некоторые диагностические методы противопоказаны при беременности, поскольку опасны для будущего ребенка. Нельзя проводить биопсию, лапароскопию, сканирование печени.
- Часть методик не дает достаточно информации. При пальпации печень практически не прощупывается, а биохимический анализ крови не может отобразить изменения, вызванные заболеванием.
При первом подозрении на гепатоз беременных, необходимо обратиться к врачу.
У будущей мамы производится забор крови на анализ, проводится УЗИ печени, а иногда и других органов. О развитии заболевания будет свидетельствовать повышенное количество желчных кислот в крови и увеличение желчного пузыря на снимке УЗИ.
Чем опасен гепатоз при беременности?
Риск неблагоприятных последствий зависит от формы и стадии заболевания. Острый жировой гепатоз до настоящего времени остается одним из самых опасных недугов. Быстрое развитие такой формы грозит смертью матери и малыша, поэтому при ее выявлении могут рекомендоваться экстренные роды.
Холестатический гепатоз редко представляет угрозу жизни, но ухудшает эмоциональное состояние женщины и нарушает нормальный ритм сна из-за сильного зуда.
К другим возможным осложнениям гепатоза относятся:
- риск внутриутробного кислородного голодания плода; Подробнее о внутриутробной гипоксии→
- вероятность преждевременных родов;
- плацентарная недостаточность;
- увеличение риска удушья ребенка во время родов;
- повышенный риск послеродовых кровотечений.
Таким образом, женщине гепатоз доставляет осложнения и дискомфорт, которые, однако, проходят после родов. Последствия для ребенка намного серьезнее. Из-за гипоксии и асфиксии в дальнейшем возможно отставание в физическом и психическом развитии.
Методы лечения
Лечение гепатоза беременных осложняется тем, что многие сильнодействующие препараты противопоказаны. После диагностических процедур и выяснения особенностей заболевания, решается вопрос о времени родоразрешения и назначается симптоматическое лечение.
Основная роль отводится приему гепатотропных препаратов. Они защищают печень и восстанавливают отток желчи. В дополнение назначаются витамины.
Режим питания и меры профилактики
Также при лечении гепатоза важно придерживаться диеты. Легкая форма заболевания может быть устранена при помощи соблюдения правил питания. Пищу необходимо принимать часто, не менее 5 раз в день, в одно и то же время. Порции должны быть одинаковыми, небольшими, переедание строго запрещено.

Основа рациона при гепатозе – натуральная пища. Не рекомендуется употреблять еду, содержащую искусственные добавки: красители, ароматизаторы, подсластители и т. д. Все эти вещества увеличивают нагрузку на печень.
В рамках лечебной диеты запрещается употреблять:
- жирные сорта рыбы и мяса;
- соленья;
- консервы;
- копчености;
- бобовые (фасоль, горох);
- свежую выпечку;
- кофе и какао;
- грибы;
- молочные продукты с высоким процентом жирности.
В ограниченных количествах допускается виноград, охлажденные напитки, мороженое. Разрешено любое печенье, кроме сдобного, сухари и подсушенный хлеб, молочные продукты с умеренной жирностью.
Из способов приготовления оптимальны запекание и готовка на пару.
В блюдах можно сочетать овощи, фрукты, крупы, нежирные сорта мяса и рыбы. В качестве десертов рекомендуются желе, муссы, творожные запеканки с добавлением сухофруктов, ягод и орехов.
Во время беременности все органы подвергаются повышенной нагрузке и печень не исключение. Гепатоз прогрессирует в третьем триместре и при своевременном лечении не приносит вреда ни матери, ни ребенку.
При наличии факторов риска, таких как наследственность, заболевания ЖКТ, гепатоз во время предыдущей беременности, стоит сделать упор на профилактику заболевания. Мерами предупреждения являются: соблюдение диеты, прием витаминно-минеральных комплексов и желчегонных препаратов (по назначению врача).
Автор: Ольга Ханова, врач,
специально для Mama96.ru
Полезное видео о гепатозе беременных